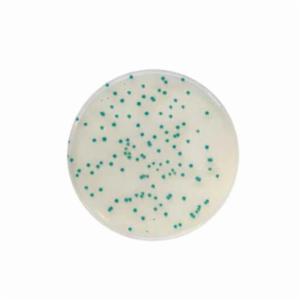
Biokar Supplément sélectif RHAPSODY 10 vials pack qsp 500 mL BS08908 Biokar Supplément sélectif RHAPSODY 10 vials pack qsp 500 mL BS08908
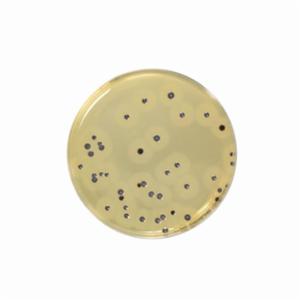
Biokar BAIRD-PARKER RPF Agar - Pre-poured medium 120 boîtes Ø 55 mm BM20408 Biokar BAIRD-PARKER RPF Agar - Pre-poured medium 120 boîtes Ø 55 mm BM20408
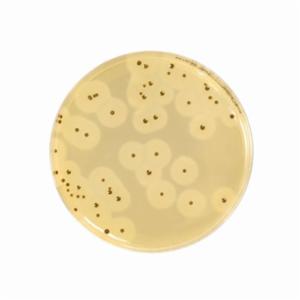
Biokar EASY Staph® Agar - Dehydrated base medium 500 grammes BK216HA Biokar EASY Staph® Agar - Dehydrated base medium 500 grammes BK216HA

Biokar
Biokar Diagnostics is the microbiology division of the Solabia group, dedicated to the development, production and selling of culture media, supplements and detection kits for microbiology laboratories.

Watch Video
Products from Biokar

Get easy access to key resources and brochures
Explore Now